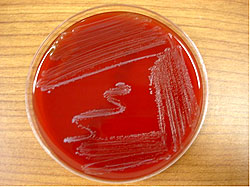
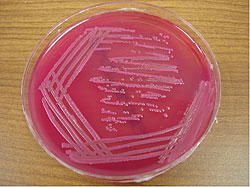

Hello Hello,
I hope you are enjoying the new year. What follows is an article about virulent infections by Dr. Harriet Burge and another about sewage contamination by Agner Martinez. I hope you'll find both articles interesting and helpful.
With best wishes,
Dave Gallup
Health Effects of the Fungi: Virulent Infections
By Dr. Harriet Burge, EMLab™ Chief Aerobiologist and Director of Scientific Advisory Board
Although we live with fungi every day, and most do us no harm, there are a few fungi that can invade the human body and cause diseases, which can range from itchy and annoying to life threatening. These fungi can be classified into four categories: virulent agents that affect all who are not immune, opportunistic agents that affect only those with some damage to their immune systems, colonizers that grow in the mucous often generated by allergic disease, and the dermatophytes that grow in human skin. In this article, we will discuss the virulent infectious agents.
Virulent agents cause infection in anyone who is appropriately exposed and who does not already have natural or acquired immunity. Natural immunity occurs when you have the disease and develop antibodies. Acquired immunity occurs when you are given vaccinations or antibodies against the organism.
Histoplasma
The fungus
Histoplasma capsulatum is the only species in the genus. It belongs to the group of fungi that produce an ascospore stage, and when producing ascospores it is called Ajellomyces capsulatus. It is a dimorphic fungus that is yeast-like at 37°C and filamentous at 25°C. The fungus grows in wet soil that is contaminated (enriched) with bird or bat droppings. It is common in the tropics, and in the Midwestern U.S. (in the Ohio and Mississippi river valleys). Spore dissemination occurs when contaminated soil is disturbed. Notable outbreaks have occurred when people have attempted to clean up starling roosts. It only occurs indoors when contaminated soil is brought in or blown in through windows.
Histoplasmosis
There are two varieties of Histoplasma capsulatum: H. capsulatum var. capsulatum which primarily cause lung disease, and H. capsulatum var. duboisii which invades skin and bones. The latter is common in Africa.
In the U.S., histoplasmosis is primarily a respiratory disease that generally goes unnoticed (i.e., is subclinical). Approximately 250,000 people per year contract histoplasmosis. These people develop natural immunity (have Histoplasma specific antibodies). Many people who have lived in the Midwest have natural antibodies to Histoplasma. In immunocompromised or elderly people, the disease can spread throughout the body and is often fatal.
Blastomyces
The fungus
Blastomyces dermatitidis is the only species in the genus. Like Histoplasma, Blastomyces is an ascomycete; the sexual stage is called Ajellomyces dermatitis. Also like Histoplasma, Blastomyces grows in dirt contaminated with bird droppings, and on wood buried in soil. It is especially common in the Mississippi river valley. It has not been recovered from any indoor environment. Spore dissemination probably occurs when contaminated soil is disturbed.
Blastomycosis
In the U.S. blastomycosis is rare. Only 12 human outbreaks have been reported. There may be unrecognized cases that cannot be reported since the disease is unrecognizable. It may occur as a self-limiting lung infection, or may spread to organs (including skin) and bones. The disseminated form, if untreated, is usually fatal. Blastomycosis also occurs in dogs.
Coccidioides
The fungus
The genus Coccidioides includes two species: C. immitis, and C. posadasii. C. immitis is endemic in the California San Joaquin Valley while C. posadasii occurs throughout the southwestern desert. The sexual stage is unknown. Coccidioides grows in hot dry alkaline soil and is often found in animal burrows. Spores are spread during dust storms, or mechanical disturbance of the soil.
Coccidioidomycosis
Both species of Coccidioides produce the same disease. Most cases of coccidioidomycosis are subclinical. When symptoms occur, the disease is called Valley fever and is an acute fungal pneumonia. Disseminated disease may occur in the immunocompromised.
Other systemic infectious fungi
None of the other virulent infectious fungi are common in the U.S., and, in fact, when cases are seen the patient has been in an endemic area. Paracoccidioides brasiliensis occurs in South America. Infection with Penicillium marneffei occurs primarily in Southeast Asia.
Reference:
1. NIOSH: Histoplasmosis
2. MedlinePlus Medical Encyclopedia: Coccidioidomycosis
3. MedlinePlus Medical Encyclopedia: Blastomycosis
E. coli and Enterococcus spp. as related to Sewage Contamination
By Agner Martinez, EMLab™ Analyst
Contamination with sewage or wastewater can originate from a variety of sources, including leaking and overflowing sanitary sewer systems, wastewater treatment facilities, leakage from septic tanks, and fecal matter associated with storm runoff from areas with high densities of wildlife, pets, or livestock. Exposure to this contamination elevates the risk of contracting gastrointestinal and other related diseases, which makes the need of testing for indications of sewage contamination very important.
The USEPA has published the following list of common pathogens that might be spread by sewage contamination. Some of these conditions are rare in the USA, but common in other countries.
Bacteria
Vibro cholera
Salmonella typhi
Salmonella other species
Shigella species
Campylobacter
Proteus species
Coliform species
E. coli 0157
Clostridium species
Pseudomonas species
Tuberclebacilli
Leptospira
Yersinia enterocolitica
|
|
Diseases
Cholera (not applicable in the UK)
Typhoid and other enteric fevers
Food poisoning
Bacterial dysentery
Gastro-enteritis
Diarrhea
Diarrhea
Gastro-enteritis, renal failure
Botulism
Local infection
Tuberculosis
Leptospirosis (Weil's disease)
Gastro-enteritis
|
| |
Viruses
Infectious Hepatitis
ECHO viruses
Coxsackie virus
Polio virus
Epidemic gastroenteritis virus
Small round viruses(SRV's)
|
|
Diseases
Inflammation of the liver
Enteric diseases and the causative
Agents of aseptic Meningitis
Poliomyelitis
Gastro-enteritis
Gastro-enteritis
|
| |
Parasites
Entamoeba histolytica
Balantidium coli
Isospora hominis & others
Giardia lamblia
Crytosporidium
Pinworms (eggs)
Tapeworms
Liver & intestinal flukes
|
|
Diseases
Amoebic dysentery
Balantidial dysentery
Coccidiosis
Diarrhea
Epidemic diarrhea
Ascariasis
Tapeworm infestation
Liver & intestinal infection
|
| |
Historically, a variety of organisms have been used as indicators of fecal contamination but many of them have been questionable because they can be found naturally in environmental samples, even in the absence of fecal contamination. Example of this is the bacteria included in categories such as fecal Streptococci, total coliforms, and fecal coliforms. Escherichia coli and Enterococcus spp. are bacteria that occupy the gut of warm blooded animals, including humans, thus their presence can be considered an indication of some kind of fecal contamination.
E. coli is a member of the family Enterobacteriaceae, which includes many genera, including known pathogens such as Salmonella, Shigella, and Yersinia. Microscopically the cells of these organisms generally appear as Gram-negative cocobacilli; or straight rods with rounded ends. Enterobacteriaceae ferment glucose, grows on MacConkey agar, is oxidase-negative, and, with rare exceptions, reduces nitrates. Although most strains of E. coli are not regarded as pathogens, they can be opportunistic pathogens that cause infection in immunocompromised hosts. There are also pathogenic strains that when ingested, can cause gastrointestinal illness in healthy humans.
The Enterococci are catalase-negative Gram-positive cocci that occur singly, in pairs, or in short chains. They are normal residents of the gastrointestinal and biliary tract and, in lower numbers, of the vagina and male urethra. They can be found in soil, vegetation, and surface water, probably due to contamination by animal excrement. Enterococci are capable of growing at a range of temperatures from 10°C to 45°C, and can live in a variety of environments that would be adverse to other bacteria. A wide variety of enterococcal species have been isolated from human infection, but E. faecalis and E. faecium predominate as the two species that are most commonly encountered.
Figure 1: Enterococcus spp. growth in TSA agar.
Copyright © 2007 Environmental Microbiology Laboratory, Inc.
|
|
Figure 2: E. coli growth on McConkey agar.
Copyright © 2007 Environmental Microbiology Laboratory, Inc.
|
The fact that E. coli and Enterococci originate in elevated numbers only in the lower intestines of warm-blooded animals makes them the best indicators of fecal contamination, and the possible presence of gastrointestinal pathogens. The testing for these indicator bacteria is also less expensive and easier than monitoring for pathogens, making them useful as a rough measure of the quality of the water or other materials that might be ingested by people.
For additional information, read our past article "Why Should I Test for Sewage Contamination?"
References:
1. Betty A. Forbes, Daniel F. Sahm, Alice S. Weissfeld. 2002. Bailey & Scott's Diagnostic Microbiology, Eleventh Edition: Mosby, Inc, St. Louis, Missouri.
2. Elmer W. Koneman, Stephen D. Allen, William M. Janda, Paul C. Schreckenberger, Washington C. Winn, Jr. 1997. Color Atlas and Textbook of Diagnostic Microbiology, Fifth Edition: Lippincott, Philadelphia, PA.
3. Environmental Protection Agency
4. Centers for Disease Control